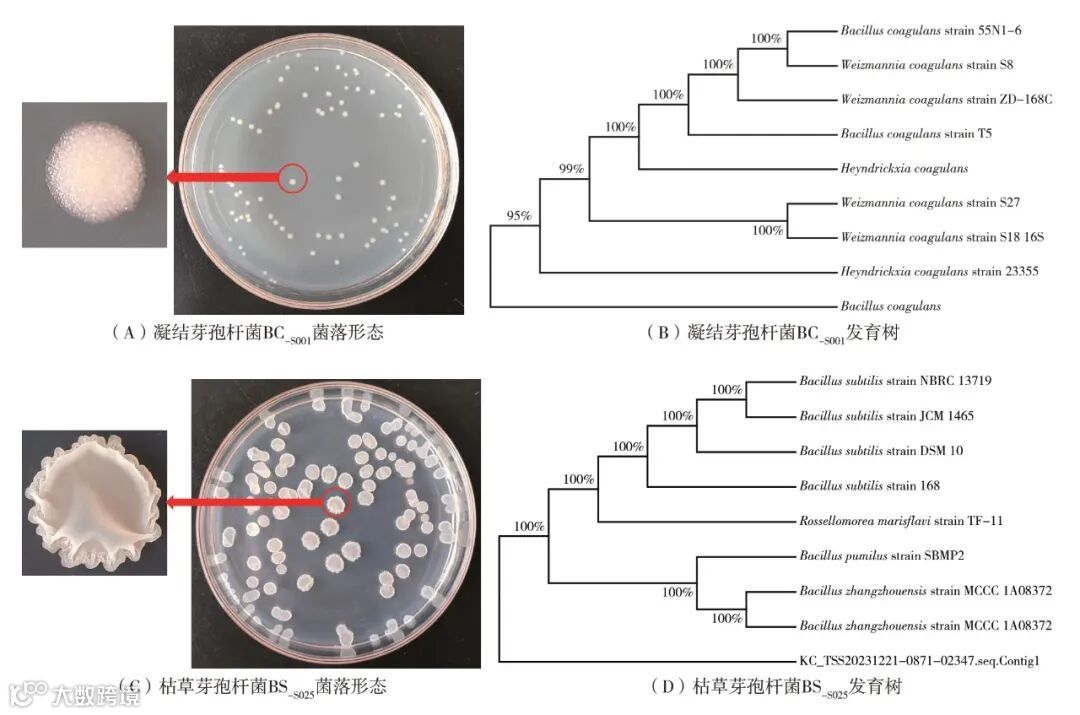
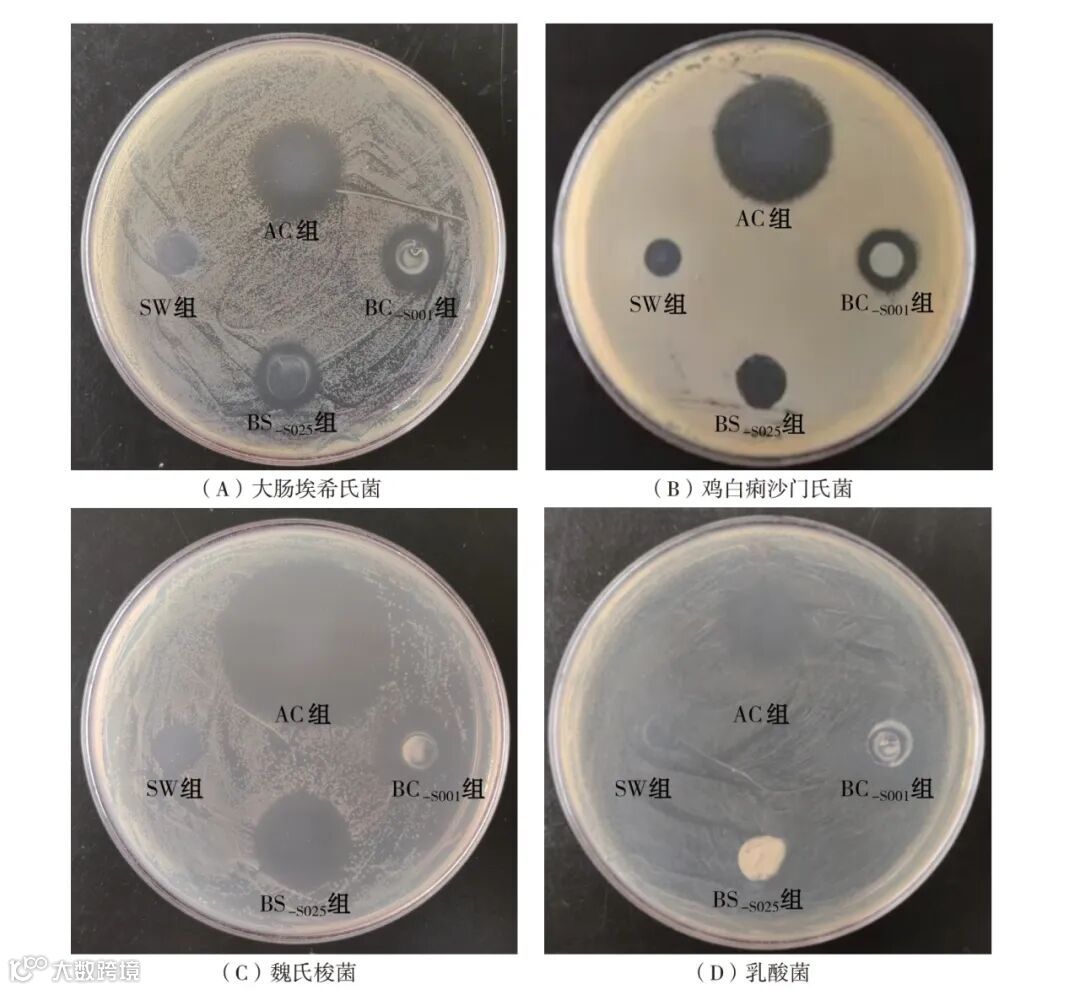
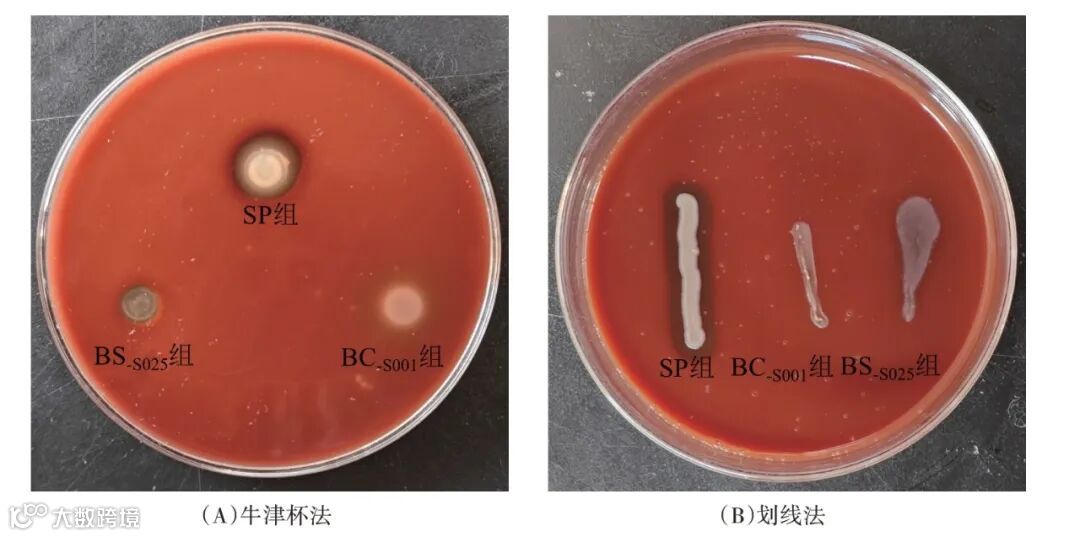

作者:王雪艳 杨 睿 苗华彪 王乙茹 何 雪 王 娜 安清聪 程志斌
世界卫生组织(WHO)定义益生菌为“适量摄取后,对机体健康能发挥有益作用的活的微生物”[1]。大量动物饲养试验表明,饲用益生菌制剂通过饲料进入肠道,发挥调节肠道菌群、促进营养吸收、增强肠道免疫、缓解炎症等多种益生性能[2-7],改善了畜禽生产性能,是禁抗、减抗趋势下极具应用价值的功能性饲用添加剂[8-10]。当前我国农业农村部《饲料添加剂品种目录(2013)》规范可用的益生菌已达34 种,不仅不同益生菌的益生性能有差异,同种益生菌的不同菌株,其益生性能可能也有较大差异,这是当前行业、企业选用饲用益生菌制剂的困惑之一。
诚然,通过动物饲养试验可选到适合的益生菌制剂产品,但饲养试验结果易受试验动物、养殖条件、试验设计等诸多因素干扰,且饲养试验周期长、效率低、费用高[11]。因此,很多专家学者在摸索科学、高效的饲用益生菌益生性能的体外评估指标与方法,以提高后续动物试验的可重复性和研发效率[12-13]。鉴于此,试验以当前行业应用较多的饲用凝结芽孢杆菌制剂、枯草芽孢杆菌制剂为研究对象,开展菌株的鉴定、菌株的体外抑菌性能、菌株的生长曲线、制剂的稳定性等主要体外益生性能的评估,以期为饲用益生菌在饲料工业及畜禽养殖业中的高效选用,提供借鉴。
材料与方法
1.1 试验材料
凝结芽孢杆菌BC-S001、枯草芽孢杆菌BS-S025,由云南农业大学动物科学技术学院程志斌老师课题组前期在云南省西双版纳州茶花鸡养殖场土壤、鸡肠道食糜及粪便中分离纯化获得[14-15]。
2个菌株均在云南师范大学生命科学院小试发酵车间,按照饲料企业和(或)养殖企业的实际应用需求,生产成100亿CFU/g的粉状饲用制剂样品,用于主要益生性能的比较评估。
1.2 评估指标及方法
从制剂样品中活化、挑取单一菌落,进行菌株的鉴定、体外抑菌性能、β-溶血、生长曲线等主要益生性能的评估;同时,对制剂进行稳定性的评估。
1.2.1 菌株的鉴定
凝结芽孢杆菌BC-S001与枯草芽孢杆菌BS-S025菌落形态的鉴定,分别参照肖明霞[14]、袁丽红[15]的方法;分别参照肖明霞[14]、袁丽红[15]的方法构建出菌株发育树。
1.2.2 菌株的体外抑菌性能
设置无菌纯化水组(SW 组)和金霉素组(AC 组),采用牛津杯体外抑菌方法,测定抑菌圈直径(DIZ),比较评估凝结芽孢杆菌BC-S001、枯草芽孢杆菌BS-S025对大肠埃希氏菌(Escherichia coli.)CGMCC 1.8359、鸡白痢沙门氏菌(Salmonella pullorum)BNCC 124693、魏氏梭菌(Clostridium perfringens)C57-1、乳酸菌(Lactobacillus acidophilus)LT2 的抑制作用。具体的操作步骤参考王雪艳等[16]的报道。
1.2.3 菌株的β-溶血试验
以鸡白痢沙门氏菌为对照组(Salmonella pullorum,SP 组),采用牛津杯法和划线法,观察BC-S001和BS-S025两菌株对去纤维鸡血的溶血现象。
① 牛津杯法。参照柳成东等[17]的报道,在预先制备的血琼脂营养培养基上放置3 个牛津杯,分别注入200 μL培养好的3组(SP组、BC-S001组、BS-S025组)的菌液,放置12~24 h后,观察比较3个处理组的溶血情况。
② 划线法。参照孔素芬等[18]的报道。用接种环,蘸取培养好的3 组(SP 组、BC-S001组、BS-S025组)的菌液,在预先制备的血琼脂营养培养基上划线,观察比较溶血情况。
1.2.4 菌株的生长曲线
菌株的生长曲线测定,参考肖明霞[14]、袁丽红[15]的报道。挑取活化的BC-S001、BS-S025,分别于改良MRS培养液、LB 培养液中扩培24 h。按照1%接种量接种,置于37 ℃摇床中培养48 h,期间每隔4 h 取2 mL菌液样品用于吸光度值(OD 值)检测,检测波长600 nm。根据吸光度值,绘制2株菌的生长曲线。
1.2.5 制剂的稳定性
分别采用实验室水浴热处理法、制粒生产加工法,以菌数存留率为指标,评估饲用凝结芽孢杆菌制剂、枯草芽孢杆菌制剂的稳定性。
① 水浴热处理损失评估。采用平板计数法检测凝结芽孢杆菌制剂、枯草芽孢杆菌制剂的初始菌数,具体检测的步骤,凝结芽孢杆菌菌数检测参考《饲料添加剂 凝结芽孢杆菌(T/CSWSL 022)》[19]、枯草芽孢杆菌菌数检测参考《饲用微生物制剂中枯草芽孢杆菌的检测(GB/T 26428)》[20];在此基础上,将2 个制剂粉样溶于水后,90 ℃、10 min水浴热处理,进一步检测存留菌数,评估存留率。
水浴热处理存留率(%)=存留菌数/初始菌数×100
② 制粒加工损失评估。按照饲料企业全价配合饲料加工的一般条件,按0.1%的添加量,将2 个制剂样品制成肉鸡颗粒饲料,制粒温度为80 ℃。分别在混合机、颗粒机的出口处,取粉料和颗粒料样品(各3 份、3 个重复)。检测混合机粉样中菌数、颗粒料中菌数。具体检测的步骤,凝结芽孢杆菌菌数检测参考《饲料添加剂 凝结芽孢杆菌(T/CSWSL 022)》[19]、枯草芽孢杆菌菌数检测参考《饲用微生物制剂中枯草芽孢杆菌的检测(GB/T 26428)》[20]。制粒加工损失评估采用的存留率指标。
制粒加工存留率(%)=颗粒料中菌数/混合机粉样中菌数×100
1.3 统计方法
抑菌性能的抑菌圈直径数据采用LSD 法多重比较,稳定性的存留率数据采用T 检验法,用SPSS 21.0进行分析,P<0.05表示差异显著。
结果与分析
2.1 菌株的鉴定
由图1(A)可知,该菌落形态呈扁平状、乳白色,表面凸起,边缘整齐,不透明。将16S rDNA 测序所得菌株的基因序列在NCBI 中经Blast 比对,与Bacillus coagulans strain 55N1-6 相似度高达99.86%,序列与凝结芽孢杆菌聚为一簇[图1(B)],确定该菌株为凝结芽孢杆菌。
由图1(C)可知,该菌落边缘光滑,中间隆起,有不规则皱褶,整体呈白色。将16S rDNA测序所得菌株的基因序列在NCBI 中经Blast 比对,与Bacillus subtilis strain JCM 1465相似度高达99.50%,序列与枯草芽孢杆菌聚为一簇[图1(D)],确定该菌株为枯草芽孢杆菌。
图1 凝结芽孢杆菌BC-S001与枯草芽孢杆菌BS-S025的菌株鉴定
2.2 菌株的体外抑菌性能
由表1 和图2 可知,枯草芽孢杆菌BS-S025对魏氏梭菌、乳酸菌的抑制显著高于凝结芽孢杆菌BC-S001(P<0.05)。凝结芽孢杆菌BC-S001 和枯草芽孢杆菌BS-S025对大肠埃希氏菌和鸡白痢沙门氏菌的抑制无显著差异(P>0.05)。此外,金霉素(AC组)对4个指示菌的抑制均显著高于BC-S001和BS-S025(P<0.05),无菌纯化水(SW组)对4个指示菌均无抑制作用。
表1 凝结芽孢杆菌与枯草芽孢杆菌的菌株体外抑菌性能评估

注:试验采用的牛津杯直径为7.8 mm,同行数据肩标不含有相同小写字母表示差异显著(P<0.05),含相同字母或无字母表示差异不显著(P>0.05)。
注:AC组,金霉素;BC-S001组,凝结芽孢杆菌;BS-S025组,枯草芽孢杆菌;SW组,无菌纯化水。
图2 凝结芽孢杆菌BC-S001与枯草芽孢杆菌BS-S025的菌株体外抑菌性能
2.3 菌株的β-溶血试验
由图3 可知,凝结芽孢杆菌BC-S001对去纤维鸡血细胞无溶血作用,枯草芽孢杆菌BS-S025有轻微溶血现象,而鸡白痢沙门氏菌(SP 组)对去纤维鸡血细胞的溶血明显。
注:SP组,鸡白痢沙门氏菌;BC-S001组,凝结芽孢杆菌;BS-S025组,枯草芽孢杆菌。
图3 凝结芽孢杆菌BC-S001与枯草芽孢杆菌BS-S025对去纤维鸡血细胞的溶血性评估
2.4 菌株的生长曲线
由图4 可知,凝结芽孢杆菌BC-S001组0~4 h 开始生长,>4~24 h 呈指数快速生长,>24~48 h 生长平缓。枯草芽孢杆菌BS-S025组0~36 h呈线性持续生长,>36~48 h生长平缓。

图4 凝结芽孢杆菌BC-S001与枯草芽孢杆菌BS-S025的菌株生长曲线
2.5 制剂的稳定性
由图5 可知,在制粒温度为(80±1)℃、制粒1 min的条件下,颗粒料中凝结芽孢杆菌BC-S001菌数存留率为73.01%,枯草芽孢杆菌BS-S025存留率为97.92%,制粒加工的存留率差异显著(P<0.05)。采用90 ℃水浴10 min 后,凝结芽孢杆菌BC-S001 制剂菌数存留率为86.53%,枯草芽孢杆菌BS-S025的存留率为82.41%,水浴热处理的存留率差异不显著(P>0.05)。

注:柱标不含有相同小写字母表示差异显著(P<0.05),无字母表示差异不显著(P>0.05)。
图5 饲用益生菌凝结芽孢杆菌BC-S001与枯草芽孢杆菌BS-S025制剂的稳定性
讨论
饲用抗生素改善畜禽生产性能获得行业公认,大量科学试验及生产实践总结的饲用抗生素应用优势包括:其一,有效性。尤其是金霉素等广谱抑菌抗生素,高效抑制肠道多种致病菌,是改善畜禽生产性能的根本原因[4,21-22]。其二,时效性。腹泻是养殖生产的共性问题,尤其断奶仔猪、育雏家禽腹泻率高、发病快。大量生产实践表明,饲用抗生素控制腹泻作用立竿见影、抑菌降腹泻效果快,是以往行业普遍选用抗生素的关键原因[4,21-23]。其三,稳定性。除产蛋禽料是粉料外,大部分畜禽、水产全价配合饲料为制粒颗粒料。饲用抗生素分子结构稳定,制粒加工损失少,这是饲用抗生素应用效果稳定的重要原因[23]。基于当前我国替抗、减抗的行业发展,上述饲用抗生素的应用优势提示,饲用益生菌制剂体外益生性能的高效评估也应该从有效性、时效性、稳定性三方面入手,以保障饲用益生菌制剂的应用效果。鉴于此,开展了此次饲用凝结芽孢杆菌制剂、饲用枯草芽孢杆菌制剂的主要益生性能的体外评估。
本研究选用的凝结芽孢杆菌BC-S001、枯草芽孢杆菌BS-S025在制剂样品菌株鉴定的基础上,开展了体外抑菌性能检测,以评估制剂抑菌性能的有效性。表1结果显示,枯草芽孢杆菌BS-S025对魏氏梭菌、乳酸菌的抑制作用显著高于凝结芽孢杆菌BC-S001。魏氏梭菌引发畜禽坏死性肠炎,是肠道主要致病菌[24];相反,乳酸菌是肠道最主要的有益菌类,是维持畜禽肠道菌群及机体健康的保障[25]。因此,以上结果不仅表明两株菌抑菌性能的有效性存在一定差异,也提示枯草芽孢杆菌BS-S025对肠道有益菌乳酸菌的抑制作用可能会影响其制剂产品的饲喂效果。这一结果发生的原因,值得进一步分析。
众所周知,致病沙门氏菌、溶血性大肠杆菌等常见肠道有害菌在增殖、增生过程中产生溶血素,使正常细胞破裂溶解,是破坏肠道菌群平衡、损伤肠黏膜的重要原因[15,17,26]。因此,溶血试验常用于致病菌及其致病因素的鉴定,其中β 溶血试验较为常用。β 溶血试验又称完全溶血试验,致病菌在血平板(去纤维鸡血细胞)培养生长,长出菌落周围若可观察到2~4 mm 界限分明的透明或半透明的溶血环,这是致病菌产生的溶血素使血红细胞完全溶解所致[17]。由于枯草芽孢杆菌BS-S025对指示菌乳酸菌的显著抑制作用,试验进一步以鸡白痢沙门氏菌(SP 组)为参照,对比评估了两株菌的溶血性。结果表明,对照组(SP组)溶血现象明显,凝结芽孢杆菌BC-S001 未发生溶血,枯草芽孢杆菌BS-S025 有轻微溶血。以上两株菌溶血试验结果与乳酸菌抑制作用结果吻合,均提示该株枯草芽孢杆菌BS-S025制剂饲喂幼龄畜禽可能会有一定的负面影响。另外,凝结芽孢杆菌BC-S001 对指示菌乳酸菌无抑制作用且无溶血现象的结果,可初步判定该株凝结芽孢杆菌制剂更适合饲喂幼龄畜禽。
大量研究表明,饲用益生菌在肠道增殖、增生过程的代谢产物,是发挥益生性能的根本原因[2-8,12-16]。由此可见,饲用益生菌在肠道增殖、增生需要一定时间,所分泌的代谢产物数量稳定后,才能发挥多种益生性能。鉴于此,图4 检测了凝结芽孢杆菌BC-S001 和枯草芽孢杆菌BS-S025 的生长曲线。结果表明,BC-S001生长曲线的稳定期出现在24 h之后,BS-S025 的稳定期出现在36 h 之后。这一结果表明,凝结芽孢杆菌BC-S001 活菌的生长速度快于枯草芽孢杆菌BS-S025,且凝结芽孢杆菌发挥益生性能的时效性可能更好。
中国食品科学技术学会益生菌分会2020 年撰写的《益生菌的科学共识》中强调,肠道中数量足够的益生菌才能发挥正常的益生功能[1],因此饲用益生菌制剂的稳定性是发挥有效性、时效性益生性能的前提。基于此,试验采用制粒生产加工法、实验室水浴热处理法,以菌数存留率为指标,评估了饲用凝结芽孢杆菌制剂、枯草芽孢杆菌制剂的稳定性。采用制粒生产加工法,检测2个益生菌制剂制粒后在全价颗粒料中的菌数存留率,结果显示,BS-S025 存留率为97.92%,显著高于BC-S001(73.01%);采用实验室水浴热处理法检测2 个益生菌制剂高温水浴处理后的菌数存留率结果显示,BS-S025存留率为82.41%、BC-S001存留率为86.53%,且差异不显著。制粒生产加工法、水浴热处理法用于饲用益生菌制剂的稳定性评估已有很多报道[27-28],本研究首次发现两个方法的评估差异性。推测实验室水浴热处理法只考虑了温度对益生菌制剂热稳定性的影响,没有考虑实际制粒生产中蒸汽压力、环模挤压、切刀剪切等诸多因素对益生菌的破坏作用。此外,实验室水浴热处理法采用的模拟温度、时间参数,也可能影响菌数的存留率。由此可见,制粒生产加工法更符合饲用益生菌制剂稳定性的评估。
结论
两个饲用益生菌制剂产品抑菌有效性有明显差异,该株凝结芽孢杆菌制剂更适合饲喂幼龄畜禽;该株凝结芽孢杆菌制剂在畜禽肠道发挥益生性能的时效性更好;制粒生产加工法比水浴热处理法更适合饲用益生菌制剂稳定性的准确评估。
参考文献及更多内容详见:
饲料工业,2025,46(17):129-135
引用格式
王雪艳, 杨睿, 苗华彪, 等. 饲用益生菌制剂凝结芽孢杆菌与枯草芽孢杆菌益生性能的体外评估[J]. 饲料工业, 2025, 46(17): 129-135.
转 载 声 明
本文为“饲料工业”独家稿件
版权合作,敬请联系gyslgy@126.com
未获书面许可,一律禁止转载!谢谢合作!

关注公众号 阅读好文章


